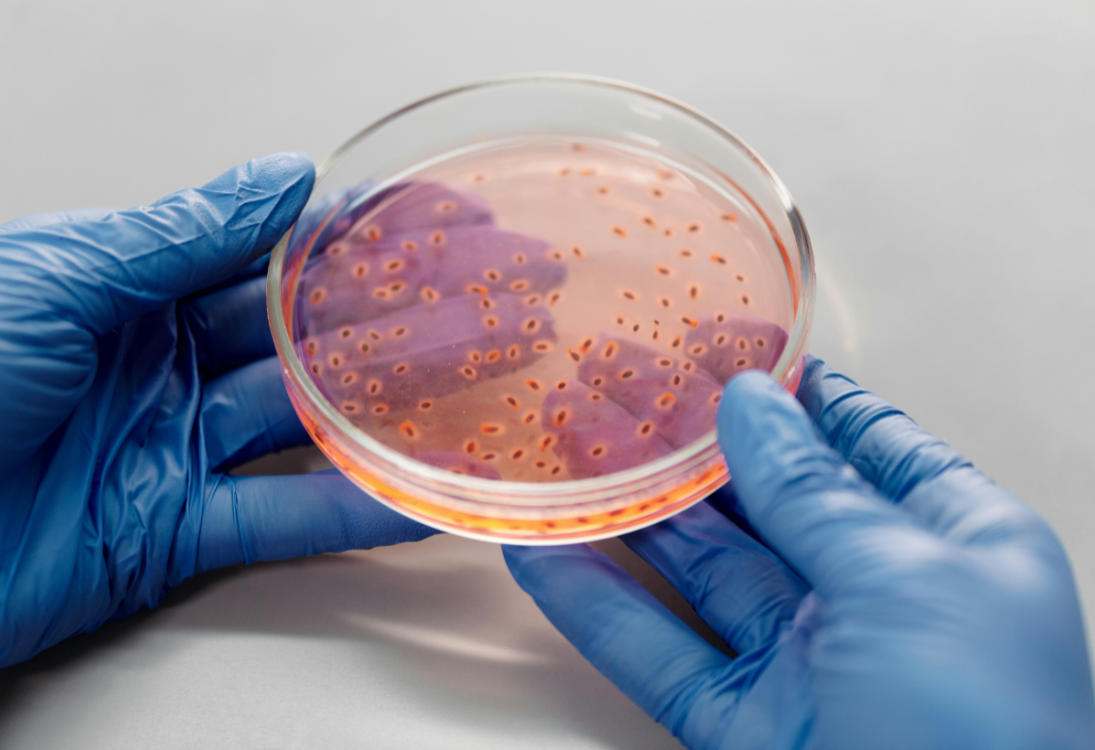

Médicos e famílias no Reino Unido alertam para atrasos no diagnóstico de cancro pediátrico

No Reino Unido, médicos e famílias estão a apelar a uma mudança urgente na formação médica e na sensibilização pública para garantir diagnósticos mais precoces de cancro pediátrico. O alerta surge após novos dados revelarem que o país está a ficar para trás na identificação atempada da doença em comparação...
Ler MaisInvestigadores alertam para os riscos de consumo excessivo de proteína em crianças com cancro

Um novo estudo do Prinses Máxima Centrum (Países Baixos) alerta para os possíveis efeitos negativos de uma ingestão muito elevada de proteína, especialmente em grupos vulneráveis como crianças com cancro. A investigação foi conduzida no grupo de Hoeijmakers e publicada na revista Nature Metabolic Health and Disease. O estudo foi realizado...
Ler MaisPortugal avança na produção de terapias com células CAR-T para aumentar o acesso a tratamentos inovadores

Já arrancou o projeto CAR T-Matters, um consórcio português que quer tornar possível a produção nacional de terapias avançadas com células CAR-T — uma forma inovadora de imunoterapia que tem mostrado resultados promissores em certos tipos de cancro do sangue. O objetivo é claro: permitir que mais pessoas em Portugal,...
Ler MaisImunoterapia testada em cães poderá salvar vidas de crianças com cancro ósseo

Uma nova imunoterapia desenvolvida para cães com cancro ósseo mostrou resultados tão promissores que poderá, já em breve, ser aprovada como tratamento para crianças com osteossarcoma. A investigação foi conduzida pela empresa biofarmacêutica OS Therapies (OST), sediada em Nova Iorque (EUA), que recorre à oncologia comparativa – uma área da ciência...
Ler MaisFalar sobre a morte ajuda a viver melhor – e a cuidar melhor

Educar sobre a morte pode parecer difícil, mas poderá ser uma estratégia eficaz para ajudar profissionais de saúde, famílias e até crianças a lidar com a perda de forma mais consciente e tranquila. Uma revisão internacional liderada pela Università di Pavia (Itália), em colaboração com a University of Bath (Reino...
Ler MaisRestrição de nutriente essencial pode travar leucemia agressiva em bebés

Uma forma rara e agressiva de leucemia que afeta sobretudo bebés pode ser travada ao limitar um nutriente essencial ao crescimento das células cancerígenas. Investigadores do Princess Máxima Center (Países Baixos) descobriram que estas células são altamente dependentes do aminoácido metionina — presente sobretudo em alimentos ricos em proteína —...
Ler MaisNovidades sobre o projeto MONALISA

Foi lançado o vídeo oficial do projeto europeu MONALISA, uma iniciativa pioneira que está a transformar a forma como se monitoriza o cancro pediátrico, em especial o neuroblastoma em fase de recidiva. Este vídeo apresenta, de forma clara e envolvente, os objetivos do projeto e o trabalho colaborativo entre instituições de...
Ler MaisCinco frases a evitar quando se comunica um diagnóstico grave

Ouvir que uma criança tem uma doença grave, como o cancro pediátrico, é um momento marcante e profundamente difícil para qualquer família. A forma como essa notícia é comunicada pode fazer toda a diferença — não só no modo como é recebida, mas também na relação de confiança que se...
Ler MaisNova esperança no neuroblastoma: terapias genéticas e celulares mostram sobrevidas de longa duração

Maria tinha apenas um ano e dez meses quando foi diagnosticada com um neuroblastoma de alto risco em estágio IV. Após mais de um ano de tratamentos intensivos nas Filipinas, que incluíram quimioterapia, cirurgia, radioterapia e transplante autólogo de medula óssea, a doença persistia. Foi então que a família descobriu...
Ler MaisNova toxina bacteriana pode estar a aumentar o risco de cancro colorretal desde a infância
A exposição precoce a uma toxina produzida por bactérias intestinais pode ajudar a explicar o aumento preocupante de casos de cancro colorretal em pessoas jovens — um padrão que os especialistas já consideram alarmante. Segundo um novo estudo publicado a 23 de abril na revista Nature, os danos provocados por...
Ler MaisSeis investigadores premiados por avanços na investigação em cancro pediátrico

Nas últimas semanas, seis investigadores do Princess Máxima Center (Países Baixos) foram premiados por trabalhos que contribuem para melhorar o tratamento de crianças com cancro. Estas distinções representam não só um reconhecimento individual, mas também um impulso importante para a missão de curar todas as crianças com cancro, garantindo a...
Ler MaisRestrição de nutriente essencial mostra-se promissora no tratamento da leucemia pediátrica agressiva

Uma forma agressiva de leucemia que afeta sobretudo bebés poderá vir a ser tratada com terapias mais direcionadas e menos tóxicas, graças a novas descobertas sobre o metabolismo das células tumorais. Os resultados de um estudo pré-clínico, hoje publicados na revista Haematologica, revelam que a restrição de um nutriente essencial...
Ler MaisNova descoberta genética melhora diagnóstico e tratamento de doenças histiocíticas em crianças

A forma como uma doença histiocítica – distúrbios sanguíneos raros – se manifesta depende do tipo de alteração genética presente. Esta foi uma das principais conclusões da investigação de doutoramento do médico e investigador Paul Kemps, realizada no Leiden University Medical Center e no Princess Máxima Center (Países Baixos). Kemps...
Ler MaisNova esperança na imunoterapia: estudo mostra que idade não afeta eficácia do tratamento

Um estudo publicado na revista Nature Communications concluiu que a imunoterapia com inibidores de checkpoints imunitários pode ser eficaz em pessoas de diferentes idades, incluindo adultos mais velhos. Esta descoberta tem implicações importantes para a investigação e tratamento do cancro, incluindo o cancro pediátrico, ao ajudar a compreender melhor como...
Ler MaisInteligência artificial antecipa risco de recidiva em gliomas pediátricos com recurso a exames sequenciais

Uma equipa de investigadores de instituições dos EUA – Mass General Brigham (EUA), Boston Children’s Hospital e Dana-Farber/Boston Children’s Cancer and Blood Disorders Center – desenvolveu um modelo de inteligência artificial (IA) capaz de prever a recidiva de gliomas pediátricos com base em múltiplas imagens de ressonância magnética realizadas ao...
Ler MaisNova estratégia mostra potencial para travar a progressão do meduloblastoma metastático

Um estudo publicado na Nature Cell Biology revelou um mecanismo que ajuda o meduloblastoma — o tumor cerebral maligno mais frequente em crianças — a espalhar-se e a crescer nas leptomeninges, as membranas que envolvem o cérebro e a medula espinal. A investigação foi conduzida por uma equipa internacional de cientistas...
Ler MaisGrupo de investigação impulsiona estudo sobre tumores pediátricos no cérebro e fígado

Desde 2024, as investigadoras Benedetta Artegiani e Delilah Hendriks lideram em conjunto um novo grupo de investigação no Princess Máxima Center (Países Baixos), dedicado a estudar como células do cérebro e do fígado em desenvolvimento se podem transformar em cancro. Esta é a primeira vez que o centro aposta num...
Ler MaisApp personalizada ajuda a reduzir fadiga relacionada com o cancro

Uma nova aplicação desenvolvida pela Rogel Cancer Center, em colaboração com a Arcascope, uma spinoff da University of Michigan (EUA), demonstrou ser eficaz na redução da fadiga causada pelos tratamentos oncológicos. Os resultados do estudo foram publicados na revista Cell Reports Medicine. A fadiga relacionada com o cancro é uma das...
Ler MaisOvos de galinha e proteínas ajudam a encontrar tratamentos personalizados para o cancro pediátrico

Investigadores no Canadá desenvolveram uma abordagem inovadora que combina o uso de ovos de galinha e análise de proteínas para encontrar tratamentos personalizados para jovens com cancro. Esta técnica foi aplicada com sucesso a um paciente com um tipo raro de cancro pediátrico resistente às terapias convencionais. Proteómica: uma nova ferramenta...
Ler MaisNovas alterações genéticas raras aumentam o risco de tumores sólidos em crianças

Investigadores identificaram alterações genéticas raras, conhecidas como variantes estruturais germinativas, que aumentam o risco de tumores sólidos pediátricos, sobretudo neuroblastoma. O estudo, publicado na revista Science, analisou o genoma de 1.765 crianças com cancro, os seus pais e 6.665 adultos saudáveis, e revelou que este tipo de alterações pode estar...
Ler Mais